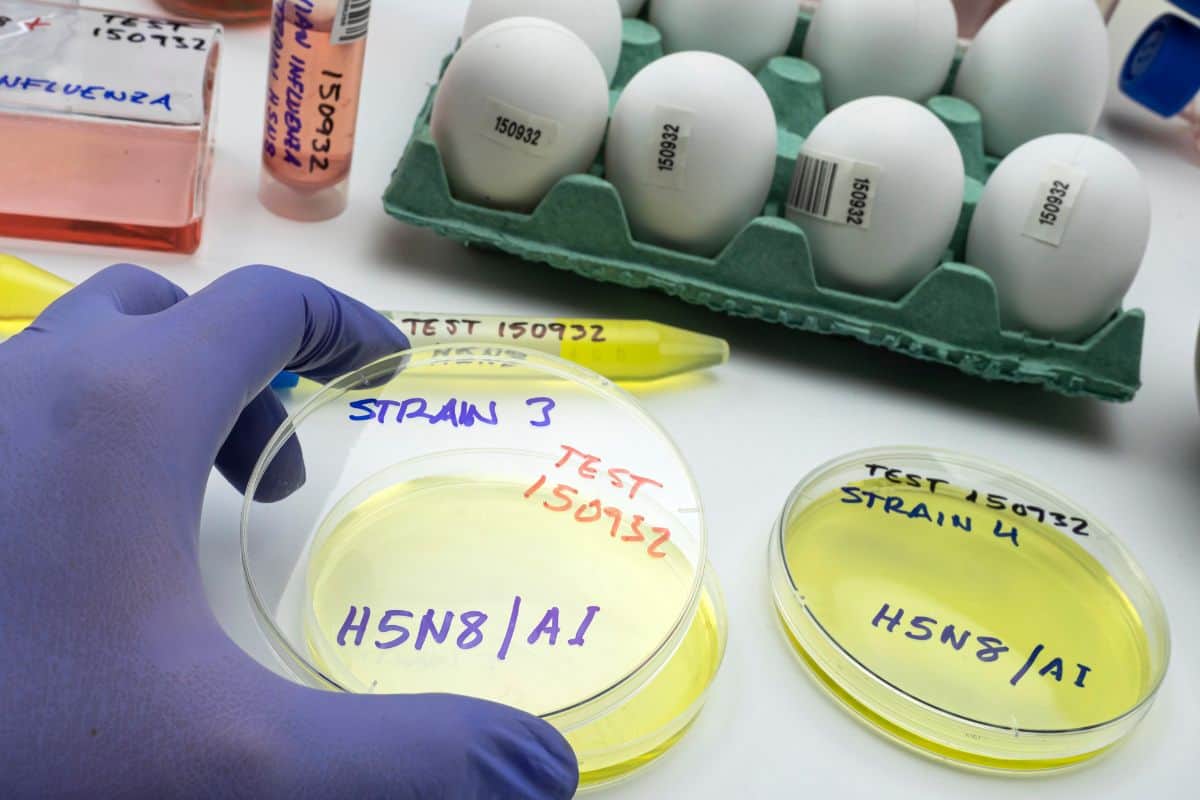
test laboratorio virus aviaria

Sviluppi inattesi e che fanno sorgere domande alle quali al momento non ci sono risposte. E’ morto il primo essere umano affetto da H5N5: cosa significa.
Sembra ieri ma allo stesso tempo qualcosa di lontano, la pandemia che tutto il mondo ha vissuto di coronavirus. Chiusi in casa, restrizioni che andavano e venivano, per non parlare della paranoia persistente di essere infettati.

Bassetti (infettivologo tra i più importanti in Italia), solo pochi giorni fa aveva lanciato l’allarme sull’Aviaria definendola la prossima pandemia e specificando: “Sarà la prossima pandemia, si tratta solo di stabilire quando”, dando per certo un’aggravarsi della situazione. Oggi arriva la notizia del primo essere umano morto per H5N5.
Aviaria, morto il primo essere umano
Negli Stati Uniti è stato identificato il primo caso umano al mondo di influenza aviaria da virus A(H5N5). La situazione è stata rivelata dall’Oms, che ha ricostruito con precisione i passaggi che hanno permesso di confermare l’infezione in un adulto residente nello Stato di Washington, una persona con condizioni di salute già fragili.
Le prime informazioni raccolte mostrano un contesto domestico in cui erano presenti pollame e uccelli da cortile, un elemento che ha indirizzato subito le indagini verso un’esposizione diretta, seppure ancora da definire in ogni dettaglio.

Gli esperti che seguono il caso hanno deciso di mantenere un controllo attivo su chiunque sia entrato in stretto contatto con il paziente nelle settimane precedenti, un passaggio fondamentale quando si affronta un virus che non ha precedenti nella specie umana.
L’elemento che ha reso la situazione particolarmente significativa è stato il risultato delle analisi genetiche. Il 20 novembre, gli specialisti dei Cdc hanno confermato che l’agente responsabile dell’infezione era proprio il virus A(H5N5), mai individuato prima nell’uomo.
I giorni che hanno preceduto la scoperta
La vicenda clinica del paziente si è sviluppata in modo rapido. All’inizio si era trattato di segnali comuni, come una febbre persistente, comparsa nell’ultima settimana di ottobre. Poi è rapidamente peggiorato arrivando fino al ricovero avvenuto nella settimana successiva. Nonostante i tentativi del personale sanitario, l’uomo è morto il 21 novembre.
Le prime analisi avevano mostrato la presenza del virus dell’influenza A, poi ulteriori test universitari avevano individuato un profilo compatibile con un ceppo A(H5), inviando immediatamente i campioni ai laboratori statali e federali per la conferma. I risultati in seguito sono apparsi chiari: si trattava per davvero di influenza A(H5N5), un agente fino ad ora associato unicamente agli animali.
La conferma ha richiesto la massima prudenza. Nonostante la gravità del caso, gli specialisti hanno voluto sottolineare che non è stato rilevato alcun segnale di trasmissione interumana. Questo significa che il virus, per il momento, non mostra la capacità di diffondersi tra le persone. Il monitoraggio continua senza pause, perché i virus influenzali sono noti per la loro capacità di cambiare in modo rapido e imprevedibile.
Le domande che al momento non hanno risposte
L’Oms ha ribadito la necessità di mantenere una rete di sorveglianza globale sempre attiva, capace di identificare tempestivamente modifiche virologiche, epidemiologiche e cliniche che potrebbero alterare l’impatto di questo tipo di agenti patogeni. Condividere i campioni è un elemento decisivo per valutare i rischi e poter mettere in campo eventuali contromisure.
L’agenzia internazionale pensa che ci sia un basso rischio per la popolazione generale, basandosi sull’assenza di ulteriori casi e sull’assenza di prove di trasmissione diretta tra esseri umani. Cambia invece la percezione del rischio per chi opera a contatto con animali malati o potenzialmente esposti, per i quali è stato definito un livello compreso tra basso e moderato.
Questa storia, iniziata come un avvenimento isolato in una tranquilla area rurale, ha già messo in moto un sistema complesso di analisi e verifiche. Gli scienziati continuano a seguire ogni dettaglio, mentre le autorità sanitarie mantengono la massima attenzione. E mentre si cerca di comprendere cosa abbia permesso a questo virus di compiere un salto così raro, resta chiaro che ogni informazione raccolta nelle prossime settimane sarà fondamentale per capire quali potenziali evoluzioni potrebbero presentarsi.





